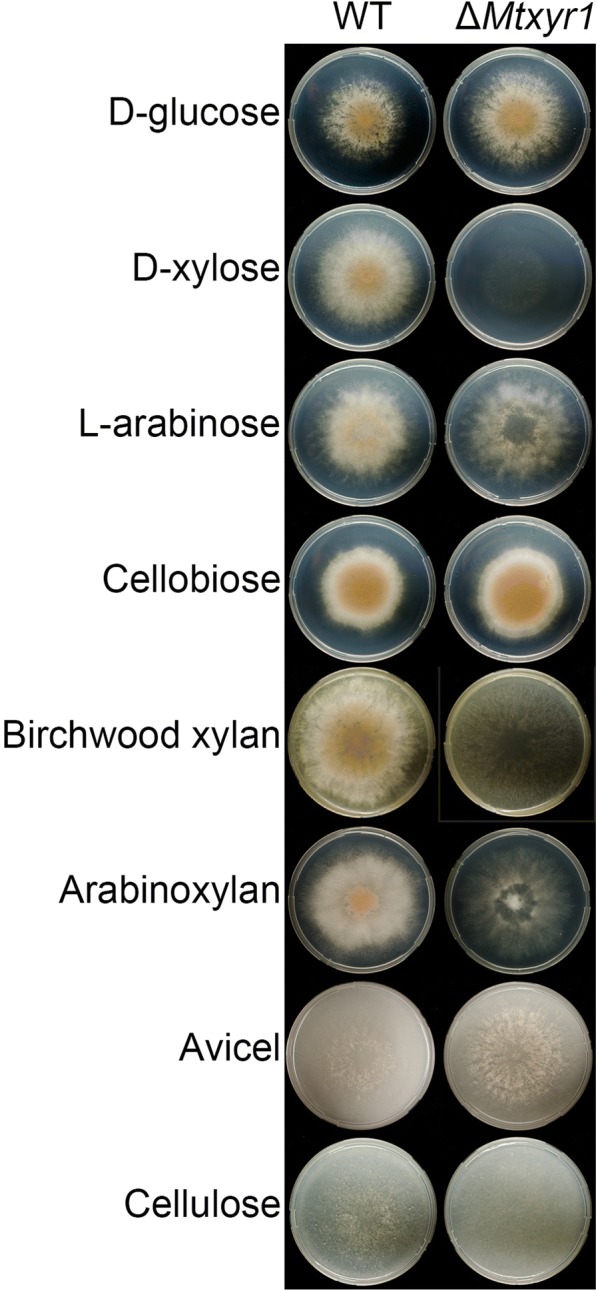
Fig. 1

Abstract
Background
Myceliophthora thermophila is a thermophilic ascomycete fungus that is used as a producer of enzyme cocktails used in plant biomass saccharification. Further development of this species as an industrial enzyme factory requires a detailed understanding of its regulatory systems driving the production of plant biomass-degrading enzymes. In this study, we analyzed the function of MtXlr1, an ortholog of the (hemi-)cellulolytic regulator XlnR first identified in another industrially relevant fungus, Aspergillus niger.
Results
The Mtxlr1 gene was deleted and the resulting strain was compared to the wild type using growth profiling and transcriptomics. The deletion strain was unable to grow on xylan and d-xylose, but showed only a small growth reduction on l-arabinose, and grew similar to the wild type on Avicel and cellulose. These results were supported by the transcriptome analyses which revealed reduction of genes encoding xylan-degrading enzymes, enzymes of the pentose catabolic pathway and putative pentose transporters. In contrast, no or minimal effects were observed for the expression of cellulolytic genes.
Conclusions
Myceliophthora thermophila MtXlr1 controls the expression of xylanolytic genes and genes involved in pentose transport and catabolism, but has no significant effects on the production of cellulases. It therefore resembles more the role of its ortholog in Neurospora crassa, rather than the broader role described for this regulator in A. niger and Trichoderma reesei. By revealing the range of genes controlled by MtXlr1, our results provide the basic knowledge for targeted strain improvement by overproducing or constitutively activating this regulator, to further improve the biotechnological value of M. thermophila.
Keywords: Myceliophthora thermophila, Xylanolytic regulator, Pentose catabolism, Xylan degradation, Cellulose degradation
Background
Plant biomass feedstocks are abundant and cheap waste materials which are increasingly used by different bio-based industries to produce a range of products. Bioethanol and biodiesel are examples of such second-generation biorefinery products which can be produced from lignocellulosic-rich biomass feedstocks [1]. These feedstocks include agricultural residues (e.g., by-products of cereal crops and sugarcane bagasse), forestry waste (e.g., wood chips and sawdust) and perennial grasses (e.g., miscanthus and switchgrass) [2, 3]. Lignocellulose is a heterogeneous and recalcitrant substrate that consists mainly of polysaccharides and lignin [4]. Its degradation requires costly processes, e.g., a thermochemical pre-treatment followed by enzymatic hydrolysis, to degrade those polysaccharides into fermentable sugars for the production of bioethanol or biochemicals [5]. Currently, there is still a need to improve available bacterial and fungal enzyme preparations [6]. To reduce the costs of the hydrolysis process, enzymes and enzyme mixtures are needed that are able to more efficiently and more completely solubilize the lignocellulosic material resulting in higher yields of fermentable sugars, above the 60% that is currently often reached.
The application of thermostable enzymes to saccharify lignocellulosic feedstocks is therefore gaining wide industrial interest [7]. Thermostable enzymes have several advantages over mesophilic enzymes, such as higher thermal stability enabling longer hydrolysis times if needed and higher specific activity at higher temperatures thus reducing the enzyme dosage needed [8]. The use of higher temperatures during saccharification (e.g., 50–60 °C) will result in better substrate solubility and lower viscosity, higher mass transfer rates and a lowered risk of contamination [9]. Therefore, applying thermostable enzymes in lignocellulose saccharification may lead to a decrease in enzyme dosage, faster conversion rates and higher sugar yields, thus reducing the overall production costs.
Myceliophthora thermophila is such a thermophilic ascomycete fungus, which is soilborne and also occurs in self-heated compost [10]. M. thermophila is known to produce a complete set of cellulolytic enzymes that act synergistically when grown on cellulose [11, 12]. A large set of lignocellulosic enzymes from M. thermophila has previously been biochemically characterized (reviewed in [13]). All enzymes have optimal activity at temperatures between 40 and 85 °C, and many of them display high thermostability [13–17]. Besides these characterized enzymes, the genome of M. thermophila contains many more genes encoding (putative) carbohydrate-active enzymes involved in oxidative and hydrolytic (hemi-)cellulose degradation. Those may also have thermophilic properties of interest for industrial applications [10, 13, 18]. This powerful potential for lignocellulose conversion has been shown when the fungus was grown on various untreated agricultural substrates [10, 19–21] and on pretreated plant biomass [19, 22]. For this reason, the industrial M. thermophila strain C1 was developed into an enzyme production platform, optimized for commercial-scale production of xylanolytic and cellulolytic enzymes to release both C5 and C6 sugars efficiently [23].
The production of lignocellulosic enzymes is mainly regulated at the transcriptional level in ascomycete fungi. Three transcription factors play a dominant, but not always the same role in the breakdown of cellulose and hemicellulose: Clr1 (ClrA) and Clr2 (ClrB) [24] and XlnR (Xyr1/Xlr1) [25, 26]. In this paper we focus on the xylanolytic activator XlnR (Xyr1/Xlr1), which thus far is the most extensively studied transcription factor involved in lignocellulose degradation in ascomycete filamentous fungi. XlnR/Xyr1 is involved in the regulation of both cellulolytic and hemicellulolytic genes in A. niger, Aspergillus oryzae and T. reesei [25, 27–29]. However, previous studies showed differences in the function of XlnR (Xyr1/Xlr1) in different filamentous fungi such as N. crassa and Magnaporthe grisea where this factor is only required for hemicellulose degradation [25, 30].
Overexpression of the xlnR homolog in the M. thermophila ATCC42464 strain (Mtxyr1) has been found to result in an increase in xylanase production, but not in cellulase production during growth on media containing an agricultural waste substrate (corncobs) or d-glucose [31]. Therefore, we decided to investigate the xylanolytic system and its regulation in this industrially relevant fungus in more detail to create the knowledge base required for a dedicated strain improvement program. While we have used a different strain than ATCC42464 and differences between strains cannot be excluded, both strains have been demonstrated to be closely related using phylogenetic means (de Vries et al. unpublished results).
Results
Deletion of Mtxyr1 affects growth on d-xylose and different xylans, and uptake of d-xylose
The complete ORF of the Mtxyr1 gene was deleted in M. thermophila C1 by targeted gene replacement via homologous recombination and verified by PCR analysis in three independent transformants (see Methods and Additional file 1: Fig. S1) with identical phenotypes. Two transformants were complemented with the wild-type gene, restoring the wild-type phenotype (Additional file 1: Fig. S2). Based on this, one of the transformants (Δxyr1.1C; further referred to as ΔMtxyr1) was used for further analyses.
ΔMtxyr1 showed hardly any growth on solid media plates with d-xylose and birchwood xylan, reduced growth on wheat arabinoxylan compared to the wild type, while growth was only slightly reduced on l-arabinose (Fig. 1). No effect on growth of ΔMtxyr1 was observed on d-glucose, cellobiose, Avicel and cellulose (Fig. 1).
Fig. 1.
Growth phenotype of the M. thermophila wild type and Δxyr1 on agar plates. The wild-type strain and the Mtxyr1 deletion mutant (ΔMtxyr1) were grown for 5 days at 37 °C on solid minimal medium containing different mono- oligo- and polymeric carbon sources
To determine whether deletion of Mtxyr1 has an effect on uptake of d-xylose and l-arabinose, the wild-type and ΔMtxyr1 were pre-grown in minimal medium with d-fructose for 48 h in liquid shake flask cultures and aliquots of mycelium were then transferred to shake flask cultures with l-arabinose or d-xylose (see Materials and Methods). d-xylose and l-arabinose concentrations were measured in the extracellular medium over time (Fig. 2). During cultivation of the wild type in minimal medium with d-xylose or l-arabinose alone, each sugar concentration decreased slowly during the first 12 h of growth (Fig. 2), but more rapidly during the next 12 h. d-xylose and l-arabinose were depleted after 24 h and 33 h, respectively. The d-xylose concentration in the extracellular medium of ΔMtxyr1 remained at a similar level during 48 h of growth (Fig. 2), while l-arabinose gradually decreased over time, yet slower than in the wild type, to be completely depleted after 48 h.
Fig. 2.
Extracellular l-arabinose and d-xylose concentration during 48 h of growth of the wild-type and ΔMtxyr1 strain in liquid cultures. Extracellular l-arabinose (red line) and d-xylose (blue line) concentration measurements of the wild type and ΔMtxyr1 grown in 50 mL liquid shake flask cultures with l-arabinose or d-xylose
The activity of endo-xylanases, β-xylosidases and cellobiohydrolases is reduced in the ΔMtxyr1 strain on d-xylose, l-arabinose and/or different xylans
Deletion of Mtxyr1 negatively affected β-xylosidase (BXL) and endo-xylanase (XLN) activities after 24 h of growth on d-xylose, l-arabinose, wheat arabinoxylan and birchwood xylan (Fig. 3). Interestingly, BXL and XLN activities were higher on l-arabinose than on d-xylose in the wild type after 24 h of growth. α-Arabinofuranosidase (ABF) activity was higher in the wild type on l-arabinose and wheat arabinoxylan compared to the other substrates. However, deletion of Mtxyr1 resulted in only a 40% reduction of ABF activity on l-arabinose, while there was an increase in the ABF activity of the mutant of 50% on wheat arabinoxylan.
Fig. 3.
Endo- and exo-acting enzyme activities after 24 h of growth of the wild-type and Δxlr1 strain on lignocellulose related substrates. Strains were grown for 24 h on d-glucose (glc), d-xylose (xyl), l-arabinose (ara), cellobiose (cel), Avicel (avi), wheat arabinoxylan (wax) and birchwood xylan (bx). Total enzyme activities were measured in culture filtrate samples as described in “Materials and Methods”. One unit of activity is defined as 1 µmol pNP (or azo dye) released from the substrate per minute per mL culture filtrate
We observed no reduced activities of β-glucosidases (BGL) and endo-glucanases (EGL) in ΔMtxyr1 after 24 h of growth on all substrates (Fig. 3). EGL activity was only detected in 24 h samples of both the wild-type and ΔMtxyr1 grown on l-arabinose and Avicel and in ΔMtxyr1 on wheat arabinoxylan. Deletion of Mtxyr1 resulted in a strong reduction in cellobiohydrolase (CBH) activity levels after the 24 h transfer on d-xylose and l-arabinose, but CBH activity was not or only weakly affected on cellobiose and Avicel. The cellulolytic enzyme activities are higher in the deletion strain on Avicel (1.5- to 2-fold for BGL and CBH).
MtXyr1 is mainly involved in regulation of expression of xylanolytic genes on both d-xylose and l-arabinose
RNA-seq was used to study the effect of the Mtxyr1 deletion on transcript levels of genes encoding Carbohydrate Active enZymes (CAZymes). The wild-type and ΔMtxyr1 strains were pre-grown in CM medium containing 2% d-fructose and aliquots of the mycelium were transferred for 2 h to minimal media containing 25 mM d-glucose, d-xylose or l-arabinose and for 2 and 8 h to minimal medium containing 1% wheat arabinoxylan. These time points were chosen to reflect the initial response (2 h) of the strains to the new conditions selected and how this response alters over time (8 h).
First, we studied the transcript levels of the CAZy genes that contain at least one predicted auxiliary activity (AA), carbohydrate esterase (CE), glycoside hydrolase (GH) or polysaccharide lyase (PL) domain (Additional file 2). A selection was made of the CAZy families that are known or predicted to be involved in plant polysaccharide degradation in Aspergillus nidulans [32]. A cutoff fold change of the data from the mutant compared to the wild type of > 2.0 and a p value of ≤ 0.01 was used to identify differentially expressed genes (Fig. 4 and Additional file 2). Only genes expressed above 5 RPKM in at least one sample were included in the expression profile analysis in the next paragraphs.
Fig. 4.
Venn diagram showing the JGI numbers, CAZy classifications and (determined or predicted) enzyme activities encoded by differentially expressed genes (DEGs) expected to be involved in plant cell wall degradation. The CAZy genes that are up-regulated (> twofold, p value > 0.01) in the 2 h d-xylose or l-arabinose samples compared to the 2 h d-glucose samples of the M. thermophila wild-type strain are designated ‘d-xylose induced’ or ‘l-arabinose induced’ genes. The MtXyr1 dependent genes are genes down-regulated (> twofold, p value > 0.01) in the ΔMtxyr1 strain on d-xylose or l-arabinose compared to the wild-type strain on d-xylose or l-arabinose. The genes containing an asterisk are genes that were up-regulated in the ΔMtxyr1 strain. The graphs show the gene expression patterns for the genes of each of the seven groups. DEGs were grouped and of each group the average RPKM per conditions was calculated and plotted in a graph (y-axis: RPKM value and x-axis: strain and substrate. W = wild-type strain, Δ = ΔMtxyr1 strain, G = 2 h d-glucose, X = 2 h d-xylose and A = 2 h l-arabinose). The enzyme activities were predicted based on manual annotation and phylogenetic analysis (see Additional file 2 for annotation results and enzyme abbreviations). In bold, the enzymes that have been characterized in the M. thermophila C1 strain. The color scheme (see legend) represents the specific plant polysaccharide the enzyme is predicted to act on in pink, orange, yellow, blue, green and purple. In gray (various), the enzymes that act on more than one specific plant polysaccharide. If there is no color assigned, the substrate of which the enzyme is active on remains unknown
Transcript levels of 34 genes were induced on d-xylose compared to d-glucose in the wild type, while 15 of these genes were also induced on l-arabinose (Fig. 4). Most genes induced on both pentoses are known/predicted to be involved in xylan degradation. The 20 CAZy genes that are only induced on d-xylose are known/predicted to be involved in xylan, cellulose and starch degradation (the genes of group 1 and 6, see Fig. 4).
Transcript levels of the CAZy genes of group 1, 2 and 3 were all significantly decreased in ΔMtxyr1 (Fig. 4).
As expected, this group consists of genes encoding hydrolytic enzymes (GH10, GH11, GH43) involved in xylan degradation, but remarkably also contains a large number of LPMO’s. The expression of 6 out of 24 LPMO genes was lower in ΔMtxyr1 on d-xylose (Fig. 4, group 1). Two of these group 1 AA9 genes, encoding MtLPMO9A and MtLPMO9B from M. thermophila C1, were studied before and were shown to be active toward regenerated amorphous cellulose (RAC) and cellulose, whereas MtLPMO9A was also active toward xylan associated with RAC, xyloglucan and mixed glucan [33].
Group 2 contains genes of which transcript levels were decreased in ΔMtxyr1 on both d-xylose and l-arabinose (Fig. 4). Almost all genes encode main chain cleaving and accessory enzymes involved in xylan degradation, except for a predicted GH2 β-mannosidase and a predicted GH12 xyloglucan-specific endo-glucanase. Group 3 contains genes that had low RPKM values (between 5 and 30), but they were l-arabinose induced and transcript levels were significantly decreased in ΔMtxyr1 on l-arabinose. Most genes of this group are involved in xylan and pectin degradation, for example those encoding the α-L-arabinofuranosidases Abf3 and Abn4, and the feruloyl esterase FaeA1 [34, 35].
Genes that were not dependent on MtXyr1 are presented in group 4, 5 and 6 (Fig. 4). Group 4 consists of a set of genes only induced on l-arabinose of which the transcript levels were not influenced by MtXyr1. These genes mainly encode arabinan- and arabinoxylan-degrading enzymes. Group 5 includes three genes that encode a GH7 cellobiohydrolase (Cbh1a), a predicted GH13_3 α-amylase and a predicted PL1_10 pectate lyase which show increased transcript levels on both d-xylose and l-arabinose, but were not affected by deletion of Mtxyr1. Group 6 includes genes expressed in the presence of d-xylose that are not MtXyr1 dependent. Almost all those genes are involved in starch and cellulose degradation. Only one of these genes, encoding the CE1 acetylxylan esterase Axe3, is active toward acetylated xylans [36]. Three starch-degrading genes (a predicted GH13 α-amylase, a starch-binding GH15 glucoamylase and a GH13 α-glucosidase) from this group were significantly up-regulated in ΔMtxyr1 on d-xylose, likely as a response to the inability to utilize d-xylose.
In summary, transcript levels of none of the endo-glucanases or cellobiohydrolases belonging to the GH5, 6 and 7 families were affected by the deletion of Mtxyr1 on d-xylose or l-arabinose at the 2 h time point (Fig. 4). The transcript level of a predicted GH5_5 endo-glucanase did increase on d-xylose, but was unaffected in the absence of Mtxyr1 (Fig. 4, group 6). There was only one GH45 endo-glucanase (Eg5) that was l-arabinose induced and down-regulated in ΔMtxyr1 on l-arabinose (Fig. 4, group 3).
Not all xylanolytic genes remain down-regulated in ΔMtxyr1 during growth on wheat arabinoxylan
To identify CAZy genes regulated by Xyr1 in M. thermophila on wheat arabinoxylan, we used RNA-seq to determine changes in mRNA levels in the wild type and ΔMtxyr1 at two time points, 2 h and 8 h. CAZy genes were considered to be time-independently regulated by MtXyr1, if at both time points the transcript levels were more than twofold decreased in ΔMtxyr1 compared to the wild type.
The expression of 24 CAZy genes was significantly lower in the ΔMtxyr1 strain at 2 h on wheat arabinoxylan (Fig. 5a). Many of these genes encode enzymes involved in the degradation of xylan, including seven known/predicted GH10 and GH11 endo-xylanases and nine predicted xylanolytic accessory enzymes. The decrease in transcript levels of a set of LPMO genes that was observed at the 2 h time point on d-xylose in ΔMtxyr1 (Fig. 4; group 1) was also observed on wheat arabinoxylan at the 2 h time point (Fig. 5a), except for one predicted AA9 LMPO (JGI: 46583). Initially, deletion of Mtxyr1 had a negative effect on transcript levels of three other CAZy genes involved in the degradation of cellulose (GH6 endo-glucanase EG6) and of xyloglucan (JGI: 109444; a predicted GH12 xyloglucan endo-glucanase) as well as in pectin degradation (JGI: 54058; a GH93 exo-arabinanase). However, transcript levels did not remain low at the 8 h time point in the ΔMtxyr1 strain (Fig. 5b). Expression of only 10 of these 24 genes remained significantly lower in the ΔMtxyr1 strain at 8 h. These CAZy genes encode mainly xylan-degrading enzymes including five known/predicted GH10 and GH11 endo-xylanases (Xyl3, Xyl7, Xyl8, JGI: 56237 and JGI: 116553), two predicted GH43 β-xylosidases (JGI: 39555 and JGI: 80104), one α-glucuronidase (Agu1) and two LPMO’s (MtLPMO9A and JGI: 92668).
Fig. 5.
The numbers of down-regulated genes per CAZy family in the ΔMtxyr1 strain on wheat arabinoxylan compared to the wild-type strain. a Down-regulated (> twofold, p value > 0.01) CAZy genes at the 2 h time point and b 8 h time point in the ΔMtxyr1 strain. Only the GH, AA, CE or PL families predicted to be involved in plant cell wall degradation per gene are shown. For additional information (enzyme abbreviations and the presence of CBM modules, see Additional file 2). In gray (various/unknown), the enzymes that act on more than one specific plant polysaccharide or of which the substrate it acts on remains unknown
Interestingly, transcript levels of many genes were significantly increased in ΔMtxyr1 compared to the wild type at both time points on wheat arabinoxylan (Fig. 6a). A total of 28 CAZy genes were up-regulated at 2 h. Among these CAZy genes, there is a set of genes predicted to be involved in starch degradation (six genes encoding two predicted GH13_40 α-glucosidases, a GH31 α-glucosidase, a GH13_5 amylase and two GH15 glucoamylases), a set of genes involved in cellulose degradation (five genes including a GH6 and a GH7 cellobiohydrolase, a GH7 endoglucanase, an AA9 LPMO and an AA8/AA3 cellobiose dehydrogenase) and a set involved in galactomannan degradation (three genes including two GH2 β-mannosidases and a GH27 α-galactosidase). The other 14 up-regulated CAZy genes in ΔMtxyr1 at 2 h were predicted to be mainly exo-acting enzymes acting on xyloglucan, pectin and various substrates.
Fig. 6.
Up-regulated CAZy genes in the ΔMtxyr1 strain during 2 and 8 h of growth on wheat arabinoxylan compared to the wild-type strain. a Up-regulated (> twofold, p value > 0.01) CAZy genes at the 2 h time point and b 8 h time point in the ΔMtxyr1 strain. In bold, 15 CAZy genes that are up-regulated at both time points. Only the GH, AA, CE or PL families predicted to be involved in plant cell wall degradation per gene are shown. For additional information, i.e., predicted or known enzyme activity abbreviations (Enzyme act.) and the presence of CBM modules, see Additional file 2. In gray (various), the enzymes that act on more than one specific plant polysaccharide
At 8 h, the number of up-regulated CAZy genes increased to 42 (Fig. 6b), including sets of CAZy genes predicted to be involved in degradation of xylan (eight genes) and pectin (13 genes). Among these genes are those encoding enzymes releasing arabinan oligomers and l-arabinose. Some of these, abn1, abn2, abf1 and abf2, were also up-regulated on l-arabinose, whereas transcript levels were unaffected by deletion of Mtxyr1 (Fig. 4; group 4).
Deletion of Mtxyr1 also affects the transcription levels of some sugar transporter-encoding genes
The effect of deleting the Mtxyr1 gene on transcript levels of 45 putative transporter genes in the M. thermophila genome was also analyzed. When all conditions and both strains were compared, 35 differentially expressed genes were detected (Fig. 7). The comparison for the three monosaccharides used is depicted in Fig. 7. The transcript levels of five putative transporter genes were induced on d-xylose and significantly decreased in ΔMtxyr1 after 2 h on d-xylose (Fig. 7 and Additional file 1: Fig S3). These include two genes of the second cluster (JGI: 108890 and 2302949) and three genes of the third cluster (JGI: 84164, 114107 and JGI: 96047) (Fig. 7). The latter gene is an ortholog of the A. nidulans d-xylose transporter (XtrD) that has been shown to be XlnR dependent in the presence of d-xylose in this fungus [37]. The two cluster 2 genes showed a highly similar transcription profile: both genes were induced on d-xylose, down-regulated in ΔMtxyr1 on d-xylose and up-regulated in the deletion strain at both time points on wheat arabinoxylan. JGI: 108890 is an ortholog of the A. niger d-galacturonic acid transporter (GatA) [38], while JGI: 2302949 is an ortholog of the d-xylose-induced transporter gene AN4148 (XtrE) of A. nidulans [37]. Transcript levels of JGI: 96047 were highly induced on d-xylose (400-fold compared to d-glucose), also induced on l-arabinose and wheat arabinoxylan (Additional file 1: Fig. S3), but down-regulated in the ΔMtxyr1 strain in all conditions. The transcript levels of the other two cluster 3 genes, JGI: 84164 and JGI: 114107, were lower in ΔMtxyr1 on l-arabinose and d-xylose. JGI: 114107 is an ortholog of the N. crassa cellodextrin/xylodextrin transporter CDT-2 gene that has been shown to be regulated by XLR-1, CLR-1 and CLR-2 during growth of N. crassa on cellulose and xylan [30, 39, 40]. JGI: 84164 is predicted to belong to the clade H of sugar transporters, including lactose permeases, cellodextrin transporters and members that are able to transport melezitose and turanose [41].
Fig. 7.
Hierarchical clustering of significantly differentially expressed putative sugar transporter genes in the ΔMtxyr1 strain. The wild-type (wt) and ΔMtxyr1 (mut) strain were grown for 2 h on d-glucose, l-arabinose and d-xylose. The color code represents the logged expression values (RPKM + 1) of both biological duplicates (named 2.1 and 2.2). The gene column provides the identifier (JGI protein numbers) of the published genome, the clade represents the sugar transporter subgroup according to de Vries et al. [41], while the third column contains a prediction of function of the putative M. thermophila transporter gene (see Additional file 4 for more information)
There were 11 putative transporter genes induced on l-arabinose (Additional file 3). Transcript levels of the two genes belonging to cluster 4 (JGI: 95427: the M. thermophila l-arabinose transporter (MtLAT-1) and JGI: 2305795) were highly induced (a 60- and 96-fold change, respectively, compared to d-glucose) and remained unchanged in ΔMtxyr1 on l-arabinose. Transcript levels of five l-arabinose-induced transporter genes (JGI: 58642, JGI: 84164, JGI: 96047; the A. nidulans XtrD ortholog, JGI: 114107; the N. crassa CDT-2 ortholog and JGI: 2307233) decreased in the ΔMtxyr1 strain on l-arabinose.
Cluster 2, 4 and 5 include sugar transporter genes of which transcript levels highly increased in ΔMtxyr1 at 8 h on wheat arabinoxylan (Additional file 1, Fig. S3) and for several genes at both 2 h and 8 h. Clusters 6 and 7 contain lowly expressed genes and only minor changes in transcript levels occurred.
Deletion of Mtxyr1 affects the transcription of genes involved in the pentose catabolic pathway (PCP) and pentose phosphate pathway (PPP)
Deletion of Mtxyr1 significantly decreased the transcript levels of ten genes predicted to be involved in primary metabolism during growth of M. thermophila on d-xylose (Fig. 8, Additional files 1: Fig. S4 and 4). This included four genes predicted to encode the pentose catabolic pathway (PCP) enzymes: d-xylose reductase (Xyl1; JGI: 43671), xylitol dehydrogenase (Xdh1; JGI: 2293953), d-xylulose kinase (Xki1; JGI: 67060) and l-arabinose/d-galacturonic acid reductase (Lar1; JGI: 110022). Transcript levels of two pentose phosphate pathway (PPP) genes, encoding a putative transketolase (Tkt1; JGI: 2300643) and a ribose-5-phosphate isomerase (Rpi2; JGI: 89872), and four putative glycolytic genes (JGI: 39694, triose-phosphate isomerase; JGI: 84302, an alcohol dehydrogenase; JGI: 2082283, an aldose 1-epimerase and JGI: 2298452, a d-fructose-biphosphate aldolase) were also decreased in ΔMtxyr1 on d-xylose.
Fig. 8.
Schematic presentation of the expression of the genes from pentose catabolism. The figure represents a schematic view of the pentose catabolic pathway in which the (putative) M. thermophila genes involved are indicated next to the catalytic step carried out by their corresponding enzymes. The gene names are indicated above the boxes and the corresponding protein numbers from the published JGI genome of this species below the boxes. The boxes themselves reflect the expression of the genes on three substrates (d-glucose, l-arabinose and d-xylose) both in the wild type and the Mtxlr1 mutant. Expression values are expressed as log-scaled RPKM values
Reduced transcript levels of only five genes were observed in ΔMtxyr1 on l-arabinose: xki1, rpi2 and the aldose 1-epimerase gen (JGI: 2082283) and d-fructose-biphosphate aldolase (JGI: 2298452)-encoding genes mentioned above and an aldehyde dehydrogenase gene (JGI: 2140820). The expression of five out of six PCP genes (with the exception of lar1) was induced in the wild type in the presence of l-arabinose or arabinoxylan compared to d-glucose (Additional file 1: Table S1).
Deletion of Mtxyr1 also negatively affected the expression of genes predicted to be involved in the PCP and PPP during 2 and 8 h of growth on wheat arabinoxylan. Transcript levels of xyl1 were down-regulated at both 2 h and 8 h, while expression of xki1 (JGI: 67060) was only down-regulated at 2 h. The transcript levels of two PPP genes, tkt1 (JGI: 2300643) and rpi2 (JGI: 89872), were also decreased in ΔMtxyr1 on wheat arabinoxylan after 2 h.
Transcript levels of many genes were observed to be significantly increased in ΔMtxyr1 after 2 h and/or 8 h on wheat arabinoxylan, reflecting metabolism utilizing l-arabinose. These genes are predicted to be involved in central metabolism (i.e., glycolysis and the PPP), the metabolism of d-mannose, the d-galacturonic acid pathway, the L-rhamnose pathway and the Leloir pathway. Transcript levels of lar1 (JGI: 110022), rpi2 (JGI: 89872) and a triose-phosphate isomerase gene (JGI: 39694) were only increased after 8 h on wheat arabinoxylan in ΔMtxyr1.
Discussion
Fungi have developed complex mechanisms to adjust their carbon metabolism to minimize energy demands. In the presence of easily metabolized carbon sources, such as glucose, the expression of genes necessary for utilization of alternative carbon sources is repressed [42]. d-Xylose and l-arabinose are important components of the plant cell wall polysaccharides. Those pentoses are able to act as inducers of the expression of genes encoding plant biomass-degrading enzymes, through the regulation of the xylanolytic activator XlnR [26]. This activator (Xyr1 in M. thermophila) is not only involved in the regulation of CAZy-encoding genes and a set of sugar transporters, but also contributes to regulation of genes in the pentose catabolic pathway (PCP) and pentose phosphate pathway (PPP) [43–45]. Xyr1 homologs are commonly found in ascomycete fungi. However, induction and regulation of genes involved in xylan and cellulose degradation are significantly different among species [25, 30, 46]. No detailed analysis has been published to date about how this transcription factor regulates the xylanolytic system in the industrially important thermophilic fungal enzyme producer M. thermophila. In our present study, we aimed at obtaining a comprehensive understanding of how an xyr1 deletion affects gene expression in this fungal host.
Growth phenotype analysis of the ΔMtxyr1 strain revealed severely reduced growth on d-xylose and birchwood xylan. Uptake experiments using transfer of fructose pre-grown mycelia showed that d-xylose uptake was impaired in the mutant strain but l-arabinose uptake was only marginally slowed down. This correlates well with the expression results which showed that four genes involved in the PCP (xyl1, xdh1, xki1 and lar1) were significantly down-regulated, suggesting that those genes are under control of Xyr1. This is similar to what was observed in T. reesei where the deletion of Xyr1 showed a strong reduction in growth on d-xylose [47], whereas in that case the whole pathway turned out to be regulated by Xyr1 [29]. In the case of M. thermophila lad1 and lxr1, the expression levels are not affected by the Xyr1 deletion. A reduced growth on d-xylose associated with a low expression of PCP genes, xyr1, prd1, lad1 and xdh1, was also reported for the M. oryzae deletion mutant of Xlr1, although this regulator does not control the xylanolytic system [48]. On the other hand, for Aspergillus it has been demonstrated that the growth on d-xylose is only affected when the transcriptional regulators XlnR and AraR are both deleted [49], suggesting that the regulation of the PCP partially depends on XlnR.
An important response was also observed in the transcription of genes involved in the pentose phosphate pathway. Expression of the ribose 5-phosphate isomerase (rpi2)-encoding gene and a putative transketolase (tkt1) was significantly lower in the ΔMtxyr1 mutant upon transfer from fructose to d-xylose, indicating direct regulation by Xyr1. As previously proposed [44], the transcription regulators XlnR and AraR also regulate some PPP genes in A. niger.
Growth of ΔMtxyr1 on l-arabinose was slightly reduced and a lower expression of xki1 and rip2 was observed. This could be explained by the small amount of d-xylose present in commercial l-arabinose [50] and this possibly induced Xyr1-regulated genes in the wild type. There is no difference in lad1 and lxr1 expression between the reference strain and the ΔMtxyr1 mutant representing two steps of the PCP specific for l-arabinose utilization. This is the case both in d-xylose and l-arabinose, indicating that Xyr1 is not involved in l-arabinose utilization.
Reduction in growth on arabinoxylan was also pronounced in ΔMtxyr1. The transcript level of xkiA was only down-regulated at the 2 h time point, while expression of xyl1 decreased at 8 h. Since wheat arabinoxylan is a substrate mainly containing d-xylose and l-arabinose, it is likely that M. thermophila takes up d-xylose preferentially, indicating the expected profile of down-regulated Xyr1-dependent genes at early time points. We demonstrated (unpublished results) that when providing a xylose/arabinose mixture, xylose was preferentially taken up during the first 12 h of growth in the wild type. In the Mtxyr1 deletion strain, d-xylose was hardly taken up but did gradually disappear from the medium in the presence of l-arabinose indicating that uptake of d-xylose requires energy which is provided by the co-substrate.
The question whether Xyr1-dependent transporters are still involved in the slow d-xylose uptake observed under these conditions can only be answered by systematically eliminating these transporters.
Xylanolytic activities present in the culture filtrate were significantly affected in ΔMtxyr1 after 24 h of growth on d-xylose, l-arabinose, arabinoxylan and birchwood xylan. Previously, it was shown that overexpression of Xyr1 in M. thermophila ATCC 42464 mainly resulted in an increased xylanase activity both in glucose and in corncob-containing media. However, the filter paper activity and endoglucanase activities were not affected in corncob- and glucose-containing medium indicating that Xyr1 plays no or only a limited role in regulating cellulolytic gene expression [31].
To gain insight into the regulation of CAZy genes, the transcriptional responses during growth on d-glucose, d-xylose, l-arabinose and wheat arabinoxylan (2 and 8 h) were analyzed in the ΔMtxyr1 mutant (Fig. 4). Our results demonstrated that Xyr1 is required for the expression of hemicellulolytic genes and a subset of mainly AA9 LPMO genes which are usually considered to play a role in cellulose oxidation. d-xylose activates the expression of these genes (Group 1 and 2).
The xylanolytic genes comprise endo- and exo-acting encoding activities and some auxiliary functions as expected. The difference in expression profile of the genes of Group 2 and Group 1 is most likely due to d-xylose impurities present in l-arabinose in combination with differences in carbon catabolite repression of the target genes. Interestingly, among the genes in Group 1, 6 AA9 LPMOs were found representing a substantial number of the 22 AA9 LPMO genes reported before to be present in the M. thermophila genome [10]. A recent study showed that the activity of one of the lytic polysaccharide monooxygenase (MtLPMO9A) from M. thermophila C1 cleaves β-(1 → 4)-xylosyl bonds in xylan, generating oxidized xylo-oligosaccharides, whereas it simultaneously cleaves β-(1 → 4)-glucosyl bonds in cellulose having a synergistic interaction with endoglucanase I [51]. As this specific LPMO is active on xylan, our transcriptomic data suggests that other LPMOs responding to Xyr1 might also be involved in oxidative cleavage of xylan. Additionally, one GH1 β-glucosidase gene (Group 1), an endo-xyloglucanase and a mannosidase (Group 2) were down-regulated in the presence of d-xylose, showing that at least a few cellulolytic genes are regulated by Xyr1. Similarly, in N. crassa, Xlr-1 is absolutely required for the expression of hemicellulose genes and those involved in d-xylose metabolism, while cellulase genes are slightly affected [52]. It has been reported that two transcription factors CLR-1 and CLR-2 are the predominant regulators of the expression of cellulase-encoding genes in N. crassa [24] as is probably the case in M. thermophila. Recently, a new specific regulator MHR1 was identified in M. thermophila ATCC 42464 and the results showed that an Mtmhr1 deletion increased expression of the main cellulase genes (cbh1, cbh2, egl3) and also of xyr1. It is not yet understood whether this regulator has any connection with CRE1 and ACE1 [53].
Expression of two L-arabinofuranosidase genes (abf3, abn4) was significantly down-regulated in ΔMtxyr1 on l-arabinose (Group 3). This indicates that Xyr1 also regulates a few genes of the arabinanolytic system. However, the expression of abf1, abf2 and other arabinanolytic genes is not under control of Xyr1 (Group 4), indicating the requirement of another transcriptional regulator. In Aspergillus, the arabinanolytic regulator AraR controls the expression of genes encoding α-arabinofuranosidases (AbfA, AbfB) [54] Our results also show a group of genes involved in cellulose and starch degradation (Group 6) that were significantly up-regulated on d-xylose and are not MtXyr1 dependent.
During the early 2 h growth phase on wheat arabinoxylan, the majority of xylanolytic genes were down-regulated and a set of genes involved in starch, cellulose and pectin degradation were up-regulated in the ΔMtxyr1 strain. This might be caused by a compensation effect by other transcription factors that act in a coordinated manner to induce enzymes which would be able to recruit nutrients from other polymers over time.
Conclusions
Although in the industrial fungi A. niger, A. oryzae and T. reesei, the Xyr1 homolog is involved in regulating the expression of the xylanolytic system and at least part of the cellulolytic system, this is not the case in M. thermophila. Xyr1 seems to be predominantly restricted to the xylanolytic system, as confirmed by the extracellular enzyme profiles determined 24 h after the transfer to the different carbon sources and by the significantly reduced XLN and BXL activities in the Mtxyr1 deletion mutant. The effects of the Xyr1 deletion at the transcriptome level of the CAZy genes identifies lack or reduced expression of all core activities involved in hydrolyzing xylan.
ABF activity clearly depends on the presence of l-arabinose or on arabinoxylan and expression of the corresponding genes does not require Xyr1, but likely depends on the homolog of the Ara1 activator present in T. reesei and M. oryzae.
The transcriptome analysis upon transfer from fructose to the polysaccharide arabinoxylan carried out after 2 h and 8 h illustrates the dynamics of the adaptation process. At the 2 h time point, there is a considerable overlap both in number and identity between the Xyr1-dependent genes on d-xylose [35] and on arabinoxylan [24] compared with wild-type and the Mtxyr1 deletion strain. The number of strictly Xyr1-dependent genes reduces to ten at the 8 h time point on arabinoxylan.
Methods
Strains, media and growth conditions
All Myceliophthora thermophila strains described in this study were grown on malt extract agar (MEA) plates at 37 °C for 7 days to obtain conidia. For growth phenotypic profiling, the WT and ΔMtxyr1 strain were grown on minimal medium agar plates (pH set to 6.0) containing AspA + N (70 mM NaNO3, 7 mM KCl, 11 mM KH2PO4), 2 mM MgSO4, trace elements (174 µM EDTA, 76 µM ZnSO4·7H2O, 178 µM H3BO3, 25 µM MnSO4·H2O, 18 µM FeSO4·7H2O, 7.1 µM CoCl2·6H2O, 6.4 µM CuSO4·5H2O and 6.2 µM Na2MoO4·2H2O), 1.6% agar–agar (Merck Company, Darmstadt, Germany), 10 mM of uridine (if necessary) and 25 mM of d-glucose, d-xylose, l-arabinose or cellobiose or 1% of birchwood xylan, wheat arabinoxylan, Avicel or cellulose. All sugar substrates were purchased from Sigma-Aldrich (St. Louis, MO, USA), except for cellobiose (Acros Organics, Belgium), wheat arabinoxylan (Megazyme, Wicklow, Ireland) and Avicel (Fluka Chemicals, Buchs, Switzerland). Strains were inoculated with 2 µL containing 500 spores and grown for 5 days at 37 °C.
In the sugar consumption experiments, the WT and ΔMtxyr1 strains were pre-grown in complete medium (pH 6.0) containing AspA + NH4 (35 mM (NH4)2SO4, 7 mM NaCl, 55 mM KH2PO4), 2 mM MgSO4, trace elements (as described above), 0.1% casamino acids, 4 μg/L biotin and 2% fructose buffered with extra addition of 70 mM KH2PO4. The strains were inoculated with 1·105 spores per mL and the liquid cultures were incubated at 37 °C at 200 rpm in a rotary shaker. After 36 h of incubation, the mycelium was then transferred into shake flasks with minimal medium by filtering the pre-culture medium through Miracloth. The mycelium was quickly washed with minimal medium without sugar and approximately 1.0 g (wet weight) of mycelium was transferred to 50 mL liquid shake flask cultures. Minimal medium (pH 6.0) contained AspA + NH4, 2 mM MgSO4, trace elements, 0.1% casamino acids, 4 μg/L biotin and was buffered with 70 mM KH2PO4. In addition, 1% d-xylose or l-arabinose or a mixture of the both sugars (0.5% of each sugar) was added to the minimal medium. The liquid shake flasks were incubated at 37 °C at 200 rpm for 48 h and 2 mL medium samples were collected after 4, 8, 12, 24, 33 and 48 h.
For the extracellular activity measurements, the WT and ΔMtxyr1 strains were pre-grown in complete medium (pH 6.0) containing AspA + N, 2 mM MgSO4, trace elements, 0.1% casamino acids, 5 g/L yeast extract, 4 μg/L biotin and 1% d-glucose. Strains were inoculated with 1·105 spores per mL and incubated at 37 °C at 200 rpm in a rotary shaker. After 36 h of incubation, pre-cultures were filtered using Miracloth, the mycelium was washed with the respective complete medium (without carbon source) and aliquots of wet mycelium were transferred to liquid shake flasks with minimal medium and as a carbon source 1% of d-glucose, d-xylose, l-arabinose, cellobiose, Avicel, wheat arabinoxylan or birchwood xylan, respectively, as described above and sampled after 24 h. Minimal medium (pH 6.0) containing AspA + NH4, 2 mM MgSO4, trace elements, 0.1% casamino acids and 4 μg/L biotin was buffered by an extra addition of 70 mM KH2PO4.
For RNA-seq analysis, the WT and ΔMtxyr1 strain were pre-grown in complete medium (pH 6.0) containing AspA + NH4, 2 mM MgSO4, trace elements, 0.1% casamino acids, 4 μg/L biotin and 2% d-fructose. Strains were inoculated with 1·106 spores per mL and incubated at 37 °C at 200 rpm in a rotary shaker. After 36 h of incubation, aliquots of the mycelium were transferred to shake flasks with minimal medium and as a carbon source 25 mM of d-glucose, d-xylose or l-arabinose or 1% wheat arabinoxylan, respectively. Minimal medium (pH 6.0) contained AspA + NH4, 2 mM MgSO4, trace elements, 0.1% casamino acids and 4 μg/L biotin and was buffered by an extra addition of 70 mM KH2PO4. Mycelial samples were harvested after 2 h of incubation in all monosaccharide cultures and after 2 and 8 h of incubation in case of the wheat arabinoxylan culture. The mycelial samples were dried between tissue paper and directly frozen in liquid nitrogen for RNA extraction.
Molecular biology methods
The deletion cassette used to create the M. thermophila Δxyr1 strain was constructed by fusion PCR. To delete Mtxyr1 gene, the ORF was replaced by the coding sequence of the M. thermophila pyr5 gene in the uridine C1 auxotrophic host strain (pyr5−). In the first PCR reactions, the upstream (fragment 1; F1) and downstream (fragment 2; F2) flanking genomic region of the xlr1 gene, and the pyr5 gene (fragment 3; F3) were amplified from C1 WT genomic DNA (Additional file 1: Fig. S1).
PCRs were performed using GoTaq® Long PCR Master Mix (Promega, Madison, WI). To obtain the three fragments, all PCRs were prepared by using 12.5 μL of GoTaq Master Mix, 0.24 μM primer concentrations, 5 µg of template DNA (genomic M. thermophila DNA) and nuclease-free water to adjust the volume to 25 μL. The PCR conditions were as follows: DNA polymerase activation at 95 °C for 2 min was followed by 35 cycles of DNA melting at 94 °C for 30 s, annealing at 60 °C (F1 and F2 primer pairs) or 64 °C (F3 primer pair) for 30 s, extension at 72 °C at 1 kb per 60 s and with a final extension at 72 °C for 5 min. The flanking fragment F1 was amplified using the primer pair xyr1–5′_F (CTACTCCACGACTCCGTACTTGG) and xyr1–5′_R (ggacagcaccctgcgcgttgcctgccatggTGGAGATGGGGTCGTCAAGACC), containing the overlapping region with the pyr5 gene in lowercase letters. The flanking fragment F2 was amplified using the primer pair xyr1–3′_F (gaagcgaagcaaagtctccgtcgacCTCCTCGTGTGTAACCGTGGG), containing the overlapping region with the pyr5 gene in lowercase letters, and xyr1–3′_R (GCCACGACTTTGAGAAGCTCCC). The pyr5 fragment F3 was amplified using the primer pair pyr5_F (CCATGGCAGGCAACGCGCAG) and pyr5_R (GTCGACGGAGACTTTGCTTCGCTTC). The fusion PCR was prepared by using 12.5 μL of GoTaq Master Mix, 0.24 μM primer concentrations (primer pair xyr1–5′_F and xyr1–3′_R), the three unpurified PCR products in a mixture at equal concentrations (1:1:1 molar ratio) and nuclease-free water to adjust the volume to 25 μL. The PCR conditions were as follows: 95 °C for 2 min was followed by 35 cycles of DNA melting at 94 °C for 30 s, annealing at 65 °C or 30 s, extension at 72 °C at 1 kb per 60 s and with a final extension at 72 °C for 5 min. The fusion PCR product (Mtxyr1 deletion cassette) was purified using the Wizard® SV Gel and PCR Clean-Up System (Promega, Madison, WI) and ligated into the pJET1.2/blunt cloning vector using the CloneJET PCR Cloning Kit (Thermo Fisher Scientific, Waltham, MA, USA) according to the manufacturer’s sticky-end protocol.
After co-transformation of the M. thermophila C1 pyr5− strain with the Mtxyr1 deletion cassette (see next paragraph), deletion of the xlr1 gene was checked by PCR screening (Additional file 1: Fig. S1). Genomic DNA was obtained from three independent single deletion transformants (ΔMtxyr1.1, ΔMtxyr1.2 and ΔMtxyr1.3). The PCR screen was performed using GoTaq® Flexi DNA Polymerase (Promega, Madison, WI). The PCRs were prepared by using 5 μL of GoTaq® Flexi buffer, 1.0 μM MgCl2, 0.20 μM of primer concentrations, 0.2 mM each dNTP, 20 ng of template DNA (genomic M. thermophila DNA), 0.125 μL of GoTaq® Flexi polymerase and nuclease-free water to adjust the volume to 25 μL. The PCR conditions were as follows: 95 °C for 2 min was followed by 30 cycles of DNA melting at 94 °C for 30 s, annealing at 62 °C for 30 s, extension at 72 °C at 1 kb per 60 s and with a final extension at 72 °C for 5 min. The presence of the ORF of xlr1 was checked using the primers pair ORF_F (CAGGAAAGACCTTGCACAGC) and ORF_R (CACGGAAGTTACCGTTCTGG). The 5′ region of the xlr1 deletion cassette was amplified using the primer pair DC5_F (TCAGGACAGCGTACAAGTAGTGG) and DCpyr5_R (GTGCTCCCTATCTGACAACTCC). The 3′ region was amplified using the primer pair DCpyr5_F (GCACAGCATCTCTTGAAGCG) and DC3_R (CTGCTTGATGCTCGATATGC).
One of gene deletion mutants (ΔMtxyr1.1 strain) was complemented with the wild-type gene copy, and a complementation vector was constructed containing the ORF of the xyr1 gene with a 2000 bp promoter region and 1500 bp terminator region. The amplified PCR product was ligated into the pJET1.2/blunt cloning vector using the CloneJET PCR Cloning Kit (Thermo Fisher Scientific, Waltham, MA, USA) according to the manufacturer’s instructions.
Myceliophthora thermophila transformation
About 106 spores per mL were inoculated into 250 mL of complete medium (pH 6.0) containing AspA + NH4 (35 mM (NH4)2SO4, 7 mM NaCl, 55 mM KH2PO4), 2 mM MgSO4, trace elements (as described above), 0.1% casamino acids, 4 μg/L biotin and 2% fructose buffered with extra addition of 70 mM KH2PO4 and cultured at 37 °C at 200 rpm for 24 h. Young mycelia were harvested by vacuum filtration and washed with 100 mL NaCl/CaCl2 (0.6 M NaCl, 0.27 M CaCl2 2H2O). About 2 g of mycelium was then dissolved in a protoplasting enzyme mix (20 mg Lysing Enzymes Trichoderma harzianum, 15 mg Driselase from Basidiomycetes sp. per gram of mycelium dissolved in 5 mL of NaCl/CaCl2) and incubated in a rotary shaker at 70 rpm at 30 °C. When enough protoplasts were formed, the mixture was filtered over a sterile Miracloth and washed with 22.5 mL NaCl/CaCl2. Next, 22.5 mL of cold STC (1.2 M sorbitol, 50 mM CaCl2. H2O, 35 mM NaCl, 10 mM Tris/HCl) was added to the suspension and mixed by gently inverting the tube a couple of times. The protoplasts were collected by centrifugation (10 min, 2500 rpm, 4 °C), resuspended in 50 mL of STC and centrifuged again. The supernatant was discarded and the pellet was carefully resuspended in the remaining STC (approximately 2 mL). For transformation, 100 μL of protoplast suspension, 1 μL of 0.5 M ATA (aurintricarboxylic acid ammonium salt) was mixed with 5 μg of deletion cassette DNA and incubated for 25 min. With a 10 mL pipette 8, 8 and 18 drops of 60% PEG4000 (60% PEG4000, 50 mM CaCl2 2H2O, 35 mM NaCl, 10 mM Tris/HCl, 1 M Tris/HCl, pH 7.5) were added to the suspension and mixed gently by slowly inverting the tube between every step. After 20 min of incubation at room temperature, 50 mL of STC was added and centrifuged (10 min, 2500 rpm, 4 °C). The supernatant was removed and resuspended in the STC left over. Aliquots (0.1–0.3 mL) of transformed protoplast suspension were spread over selection plates containing 10 mM of uridine. Growing colonies were observed after 3 days at 37 °C.
Sugar consumption and enzyme activity analysis
HPLC was used to determine the sugar concentrations in the medium samples collected after 4, 8, 12, 24, 33 and 48 h. Sugar analysis was performed as described previously on a Thermo Scientific 5000 + HPLC-PAD system [55]. The data obtained are the results of two independent biological replicates and for each replicate three technical replicates were assayed. Endo- and exo-acting enzyme activities in culture filtrates of transferred mycelia of the M. thermophila WT and ΔMtxyr1 strain to liquid shake flask cultures with lignocellulose-related substrates were measured using pNP- (p-nitrophenol) linked substrates (Sigma-Aldrich, St. Louis, MO, USA) to measure α-arabinofuranosidase, β-xylosidase, β-glucosidase and cellobiohydrolase activity. Azo-CM-cellulose and Azo-wheat arabinoxylan (Megazyme, Wicklow, Ireland) were used to measure endo-glucanase or endo-xylanase activity, respectively. Exo-acting enzyme activities were determined by measuring the amount of pNP released after 30–60 min by the culture filtrate with the pNP-linked substrates and standardized against a known concentration of pNP. Activities are expressed in mU/mL. The reactions contained between 5 µL and 30 µL of culture filtrate, 10 µL 0.1% pNP-linked substrate and 25 mM sodium acetate buffer, pH 5.0, in a total volume of 100 µL. All reactions were pipetted and mixed in a 96-wells microtiter plate, incubated at 50 °C and then stopped by the addition of 100 µL 0.25 M sodium carbonate. Absorbance was measured at 405 nm in a microtiter plate reader (FLUOstar OPTIMA, BMG Labtech). Endo-acting enzyme activities were measured in 100 µL reactions as described previously [56]. Absorbance was measured at 590 nm. Activities are expressed as mU/mL. All the enzyme activity data obtained are the results of two independent biological replicates and two technical replicates.
RNA extraction and gene expression analysis
Total RNA was extracted from mycelium ground in a Tissue Lyser II (Qiagen, Venlo, the Netherlands) using TRIzol reagent (Invitrogen, Breda, the Netherlands) and purified with NucleoSpin® RNA II Clean-up kit (Macherey–Nagel) with rDNase treatment. The RNA quantity and quality were checked with an RNA6000 Nano Assay using the Agilent 2100 Bioanalyzer (Agilent Technologies, Santa Clara, CA, USA). RNA samples were single-end sequenced at BGI Tech Solutions Co., Ltd. (Hong Kong, China) using the Illumina HiSeqTM 2000 platform (http://illumina.com). Raw reads were produced from the original image data by base calling. On average, 49 bp sequenced reads were constituted, producing 596 MB raw yields for each sample. After data filtering, the adaptor sequences, reads with unknown bases (N) > 10% and low-quality reads (more than 50% of the bases with quality value < 5%) were removed. Clean reads were mapped to the genome sequence of M. thermophila v2.0 [17] using BWA/Bowtie [57, 58] with no more than two mismatches allowed in the alignment. On average, 90% of the clean reads were mapped to the genome. The gene expression level as reads per kilobase of exon per million fragments mapped (RPKM) was calculated by using the RSEM tool [59]. Differential expression was identified by CyberT Bayesian ANOVA algorithm [60]. A fold change of > 2 and p value of < 0.01 were used to identify differentially expressed genes. The heat maps were made by the “gplots” package of R software, with the default parameters: “Complete-linkage clustering method and Euclidean distance”.
The CAZymes and sugar transporter genes were extracted from the M. thermophila genome available online at the JGI MycoCosm database, https://genome.jgi.doe.gov/Spoth2 [61]. The carbon metabolism genes were identified by orthologous mapping with the well annotated genes in the Aspergillus Genome Database (http://www.aspergillusgenome.org/ [62] using a bidirectional best hit (BBH) method [63, 64].
Supplementary information
Additional file 1. Combines Table S1 and Figure S1-S4.
Additional file 2. Differentially expressed CAZy genes involved in plant cell wall degradation.
Additional file 3. Differentially expressed genes involved in sugar transport.
Additional file 4. Differentially expressed genes involved in primary metabolism.
Acknowledgements
The authors thank Joost van den Brink for technical advice.
Authors’ contributions
RPdV designed the study. DF, EB, MNdA and NCL performed the experiments. ACdSG, DF, EB, MP, JV and RPdV contributed to data analysis and writing of the manuscript. RPdV, JV and J-PM supervised the work. All authors read and approved the final manuscript.
Funding
ACdS was supported by Grant Nr. 88881.131547/2016-01 from the Coordination for the Improvement of Higher Education Personnel (CAPES/PDSE), Brazil. MNdA and DF were supported by Grants Nr. 246743/2012-3 and 246763/2012-4, respectively, of the Conselho Nacional de Desenvolvimento Científico e Tecnológico (CNPQ), Brazil. ACdSG was supported by the Coordination for the Improvement of Higher Education Personnel (CAPES/PDSE) through Grant 88881.131547/2016-01. NCL was supported by Grant 263888 from the National Council of Science and Technology of Mexico. EB was supported by a BE-Basic (The Netherlands) Grant TKIBE01003 to RPdV.
Availability of data and materials
The datasets generated and analyzed during the current study were deposited at the Gene Expression Omnibus (GEO) database [65] with Accession Number: GSE137286.
Ethics approval and consent to participate
Not applicable.
Consent for publication
Not applicable.
Competing interests
The authors declare that they have no competing interests.
Footnotes
Publisher's Note
Springer Nature remains neutral with regard to jurisdictional claims in published maps and institutional affiliations.
Ana Carolina dos Santos Gomes, Daniel Falkoski and Evy Battaglia contributed equally to this paper
Contributor Information
Ana Carolina dos Santos Gomes, Email: carolsantos218@hotmail.com.
Daniel Falkoski, Email: dlfalkoski@yahoo.com.br.
Evy Battaglia, Email: evybattaglia@gmail.com.
Mao Peng, Email: m.peng@westerdijkinstitute.nl.
Maira Nicolau de Almeida, Email: malmeida@ufsj.edu.br.
Nancy Coconi Linares, Email: n.linares@westerdijkinstitute.nl.
Jean-Paul Meijnen, Email: jean-paul.meijnen@ddna-biotech.com.
Jaap Visser, Email: j.visser@westerdijkinstitute.nl.
Ronald P. de Vries, Email: r.devries@westerdijkinstitute.nl
Supplementary information
Supplementary information accompanies this paper at 10.1186/s13068-019-1556-y.
References
- 1.Ghatak H. Biorefineries from the perspective of sustainability: feedstocks, products, and processes. Renew Sust Energy Rev. 2011;15(8):4042–4052. [Google Scholar]
- 2.van der Weijde T, Alvim Kamei CL, Torres AF, Vermerris W, Dolstra O, Visser RG, et al. The potential of C4 grasses for cellulosic biofuel production. Front Plant Sci. 2013;4(107):1–18. doi: 10.3389/fpls.2013.00107. [DOI] [PMC free article] [PubMed] [Google Scholar]
- 3.Sarkar N, Ghosh S, Bannerjee S, Aikat K. Bioethanol production from agricultural wastes: an overview. Renew Energy. 2012;37(1):19–27. [Google Scholar]
- 4.Himmel ME, Ding SY, Johnson DK, Adney WS, Nimlos MR, Brady JW, et al. Biomass recalcitrance: engineering plants and enzymes for biofuels production. Science. 2007;315(5813):804–807. doi: 10.1126/science.1137016. [DOI] [PubMed] [Google Scholar]
- 5.Sun Y, Cheng J. Hydrolysis of lignocellulosic materials for ethanol production: a review. Bioresour Technol. 2002;83(1):1–11. doi: 10.1016/s0960-8524(01)00212-7. [DOI] [PubMed] [Google Scholar]
- 6.Van Dyk JS, Pletschke BI. A review of lignocellulose bioconversion using enzymatic hydrolysis and synergistic cooperation between enzymes-factors affecting enzymes, conversion and synergy. Biotechnol Adv. 2012;30(6):1458–1480. doi: 10.1016/j.biotechadv.2012.03.002. [DOI] [PubMed] [Google Scholar]
- 7.Yeoman C, Han Y, Dodd D, Schroeder C, Mackie R, Cann I. Thermostable enzymes as biocatalysts in the biofuel industry. Adv Appl Microbiol. 2010;70:1–55. doi: 10.1016/S0065-2164(10)70001-0. [DOI] [PMC free article] [PubMed] [Google Scholar]
- 8.Viikari L, Alapuranen M, Puranen T, Vehmaanpera J, Siika-Aho M. Thermostable enzymes in lignocellulose hydrolysis. Adv Biochem Eng Biotechnol. 2007;108:121–145. doi: 10.1007/10_2007_065. [DOI] [PubMed] [Google Scholar]
- 9.Turner P, Mamo G, Karlsson EN. Potential and utilization of thermophiles and thermostable enzymes in biorefining. Microb Cell Fact. 2007;6:9. doi: 10.1186/1475-2859-6-9. [DOI] [PMC free article] [PubMed] [Google Scholar]
- 10.Berka RM, Grigoriev IV, Otillar R, Salamov A, Grimwood J, Reid I, et al. Comparative genomic analysis of the thermophilic biomass-degrading fungi Myceliophthora thermophila and Thielavia terrestris. Nat Biotechnol. 2011;29(10):922–927. doi: 10.1038/nbt.1976. [DOI] [PubMed] [Google Scholar]
- 11.Bhat KM, Maheshwari R. Sporotrichum thermophile growth, cellulose degradation, and cellulase activity. Appl Environ Microbiol. 1987;53(9):2175–2182. doi: 10.1128/aem.53.9.2175-2182.1987. [DOI] [PMC free article] [PubMed] [Google Scholar]
- 12.Bhat KM, Gaikwad JS, Maheshwari R. Purification and characterization of an extracellular β-glucosidase from the thermophilic fungus Sporotrichum thermophile and its influence on cellulase activity. Microbiol. 1993;139:2825–2832. [Google Scholar]
- 13.Karnaouri A, Topakas E, Antonopoulou I, Christakopoulos P. Genomic insights into the fungal lignocellulolytic system of Myceliophthora thermophila. Front Microbiol. 2014;5:281. doi: 10.3389/fmicb.2014.00281. [DOI] [PMC free article] [PubMed] [Google Scholar]
- 14.Katsimpouras C, Dimarogona M, Petropoulos P, Christakopoulos P, Topakas E. A thermostable GH26 endo-beta-mannanase from Myceliophthora thermophila capable of enhancing lignocellulose degradation. Appl Microbiol Biotechnol. 2016;100(19):8385–8397. doi: 10.1007/s00253-016-7609-2. [DOI] [PubMed] [Google Scholar]
- 15.Gusakova A, Sinitsyna A, Salanovicha T, Bukhtojarova F, Markova A, Ustinova B, et al. Purification, cloning and characterisation of two forms of thermostable and highly active cellobiohydrolase I (Cel7A) produced by the industrial strain of Chrysosporium lucknowense. Enzyme Microb Technol. 2005;36(1):57–69. [Google Scholar]
- 16.Ustinov BB, Gusakov AV, Antonov AI, Sinitsyn AP. Comparison of properties and mode of action of six secreted xylanases from Chrysosporium lucknowense. Enzyme Microb Technol. 2008;43(1):56–65. [Google Scholar]
- 17.Bukhtojarov FE, Ustinov BB, Salanovich TN, Antonov AI, Gusakov AV, Okunev ON, et al. Cellulase complex of the fungus Chrysosporium lucknowense: isolation and characterization of endoglucanases and cellobiohydrolases. Biochem Biokhim. 2004;69(5):542–551. doi: 10.1023/b:biry.0000029853.34093.13. [DOI] [PubMed] [Google Scholar]
- 18.Hinz SW, Pouvreau L, Joosten R, Bartels J, Jonathan MC, Wery J, et al. Hemicellulase production in Chrysosporium lucknowense C1. J Cereal Sci. 2009;50(3):318–323. [Google Scholar]
- 19.Kolbusz MA, Di Falco M, Ishmael N, Marqueteau S, Moisan MC, Baptista Cda S, et al. Transcriptome and exoproteome analysis of utilization of plant-derived biomass by Myceliophthora thermophila. Fungal Genet Biol. 2014;72:10–20. doi: 10.1016/j.fgb.2014.05.006. [DOI] [PubMed] [Google Scholar]
- 20.Matsakas L, Antonopoulou I, Christakopoulos P. Evaluation of Myceliophthora thermophila as an enzyme factory for the production of thermophilic cellulolytic enzymes. BioResources. 2015;10(3):5140–5158. [Google Scholar]
- 21.Sugden C, Bhat MK. Cereal straw and pure cellulose as carbon sources for growth and production of plant cell-wall degrading enzymes by Sporotrichum thermophile. World J Microbiol Biotechnol. 1994;10(4):444–451. doi: 10.1007/BF00144470. [DOI] [PubMed] [Google Scholar]
- 22.van den Brink J, van Muiswinkel GC, Theelen B, Hinz SW, de Vries RP. Efficient plant biomass degradation by thermophilic fungus Myceliophthora heterothallica. Appl Environ Microbiol. 2013;79(4):1316–1324. doi: 10.1128/AEM.02865-12. [DOI] [PMC free article] [PubMed] [Google Scholar]
- 23.Visser H, Joosten V, Punt PJ, Gusakov AV, Olson PT, Joosten R, et al. Development of a mature fungal technology and production platform for industrial enzymes based on a Myceliophthora thermophila isolate, previously known as Chrysosporium lucknowense C1. Ind Biotechnol. 2011;7(3):214–223. [Google Scholar]
- 24.Coradetti ST, Craig JP, Xiong Y, Shock T, Tian C, Glass NL. Conserved and essential transcription factors for cellulase gene expression in ascomycete fungi. Proc Nat Acad Sci USA. 2012;109(19):7397–7402. doi: 10.1073/pnas.1200785109. [DOI] [PMC free article] [PubMed] [Google Scholar]
- 25.Klaubauf S, Narang HM, Post H, Zhou M, Brunner K, Mach-Aigner AR, et al. Similar is not the same: differences in the function of the (hemi-)cellulolytic regulator XlnR (Xlr1/Xyr1) in filamentous fungi. Fungal Genet Biol. 2014;72:73–81. doi: 10.1016/j.fgb.2014.07.007. [DOI] [PubMed] [Google Scholar]
- 26.van Peij NN, Visser J, de Graaff LH. Isolation and analysis of xlnR, encoding a transcriptional activator co-ordinating xylanolytic expression in Aspergillus niger. Mol Microbiol. 1998;27(1):131–142. doi: 10.1046/j.1365-2958.1998.00666.x. [DOI] [PubMed] [Google Scholar]
- 27.Gielkens MM, Dekkers E, Visser J, de Graaff LH. Two cellobiohydrolase-encoding genes from Aspergillus niger require d-xylose and the xylanolytic transcriptional activator XlnR for their expression. Appl Environ Microbiol. 1999;65(10):4340–4345. doi: 10.1128/aem.65.10.4340-4345.1999. [DOI] [PMC free article] [PubMed] [Google Scholar]
- 28.Noguchi Y, Sano M, Kanamaru K, Ko T, Takeuchi M, Kato M, et al. Genes regulated by AoXlnR, the xylanolytic and cellulolytic transcriptional regulator, Aspergillus oryzae. Appl Microbiol Biotechnol. 2009;85(1):141–154. doi: 10.1007/s00253-009-2236-9. [DOI] [PubMed] [Google Scholar]
- 29.Stricker AR, Mach RL, de Graaff LH. Regulation of transcription of cellulases- and hemicellulases-encoding genes in Aspergillus niger and Hypocrea jecorina (Trichoderma reesei) Appl Microbiol Biotechnol. 2008;78(2):211–220. doi: 10.1007/s00253-007-1322-0. [DOI] [PubMed] [Google Scholar]
- 30.Craig JP, Coradetti ST, Starr TL, Glass NL. Direct target network of the Neurospora crassa plant cell wall deconstruction regulators CLR-1, CLR-2, and XLR-1. MBio. 2015;6(5):e01452-15. doi: 10.1128/mBio.01452-15. [DOI] [PMC free article] [PubMed] [Google Scholar]
- 31.Wang J, Wu Y, Gong Y, Yu S, Liu G. Enhancing xylanase production in the thermophilic fungus Myceliophthora thermophila by homologous overexpression of Mtxyr1. J Ind Microbiol Biotechnol. 2015;42(9):1233–1241. doi: 10.1007/s10295-015-1628-3. [DOI] [PubMed] [Google Scholar]
- 32.Khosravi C, Battaglia E, Kun RS, Dalhuijsen S, Visser J, Aguilar-Pontes MV, et al. Blocking hexose entry into glycolysis activates alternative metabolic conversion of these sugars and upregulates pentose metabolism in Aspergillus nidulans. BMC Genomics. 2018;19:214. doi: 10.1186/s12864-018-4609-x. [DOI] [PMC free article] [PubMed] [Google Scholar]
- 33.Frommhagen M, Koetsier MJ, Westphal AH, Visser J, Hinz SW, Vincken JP, et al. Lytic polysaccharide monooxygenases from Myceliophthora thermophila C1 differ in substrate preference and reducing agent specificity. Biotechnol Biofuels. 2016;9(1):186. doi: 10.1186/s13068-016-0594-y. [DOI] [PMC free article] [PubMed] [Google Scholar]
- 34.Kuhnel S, Hinz SW, Pouvreau L, Wery J, Schols HA, Gruppen H. Chrysosporium lucknowense arabinohydrolases effectively degrade sugar beet arabinan. Bioresour Technol. 2010;101(21):8300–8307. doi: 10.1016/j.biortech.2010.05.070. [DOI] [PubMed] [Google Scholar]
- 35.Kuhnel S, Pouvreau L, Appeldoorn MM, Hinz SW, Schols HA, Gruppen H. The ferulic acid esterases of Chrysosporium lucknowense C1: purification, characterization and their potential application in biorefinery. Enzyme Microbial Technol. 2012;50(1):77–85. doi: 10.1016/j.enzmictec.2011.09.008. [DOI] [PubMed] [Google Scholar]
- 36.Pouvreau L, Jonathan MC, Kabel MA, Hinz SW, Gruppen H, Schols HA. Characterization and mode of action of two acetyl xylan esterases from Chrysosporium lucknowense C1 active towards acetylated xylans. Enzyme Microbial Technol. 2011;49(3):312–320. doi: 10.1016/j.enzmictec.2011.05.010. [DOI] [PubMed] [Google Scholar]
- 37.Colabardini AC, Ries LN, Brown NA, Dos Reis TF, Savoldi M, Goldman MH, et al. Functional characterization of a xylose transporter in Aspergillus nidulans. Biotechnol Biofuels. 2014;7(1):46. doi: 10.1186/1754-6834-7-46. [DOI] [PMC free article] [PubMed] [Google Scholar]
- 38.Sloothaak J, Schilders M, Schaap PJ, de Graaff LH. Overexpression of the Aspergillus niger GatA transporter leads to preferential use of d-galacturonic acid over d-xylose. AMB Express. 2014;4:66. doi: 10.1186/s13568-014-0066-3. [DOI] [PMC free article] [PubMed] [Google Scholar]
- 39.Cai P, Gu R, Wang B, Li J, Wan L, Tian C, et al. Evidence of a critical role for cellodextrin transporte 2 (CDT-2) in both cellulose and hemicellulose degradation and utilization in Neurospora crassa. PLoS ONE. 2014;9(2):e89330. doi: 10.1371/journal.pone.0089330. [DOI] [PMC free article] [PubMed] [Google Scholar]
- 40.Li X, Yu VY, Lin Y, Chomvong K, Estrela R, Park A, et al. Expanding xylose metabolism in yeast for plant cell wall conversion to biofuels. eLife. 2015;4:e05896. doi: 10.7554/eLife.05896. [DOI] [PMC free article] [PubMed] [Google Scholar]
- 41.de Vries RP, Riley R, Wiebenga A, Aguilar-Osorio G, Amillis S, Uchima CA, et al. Comparative genomics reveals high biological diversity and specific adaptations in the industrially and medically important fungal genus Aspergillus. Genome Biol. 2017;18(1):28. doi: 10.1186/s13059-017-1151-0. [DOI] [PMC free article] [PubMed] [Google Scholar]
- 42.Ruijter GJG, Visser J. Carbon repression in Aspergilli. FEMS Microbiol Lett. 1997;151:103–114. doi: 10.1111/j.1574-6968.1997.tb12557.x. [DOI] [PubMed] [Google Scholar]
- 43.Battaglia E. Regulation and diversity of plant polysaccharide utilisation in fungi [PhD Dissertation] Utrecht: University Utrecht; 2011. [Google Scholar]
- 44.Battaglia E, Zhou M, de Vries RP. The transcriptional activators AraR and XlnR from Aspergillus niger regulate expression of pentose catabolic and pentose phosphate pathway genes. Res Microbiol. 2014;165(7):531–540. doi: 10.1016/j.resmic.2014.07.013. [DOI] [PubMed] [Google Scholar]
- 45.Witteveen CFB, Busink R, van de Vondervoort P, Dijkema C, Swart K, Visser J. l-arabinose and d-xylose catabolism in Aspergillus niger. J Gen Microbiol. 1989;135:2163–2171. [Google Scholar]
- 46.Benocci T, Aguilar-Pontes MV, Zhou M, Seiboth B, de Vries RP. Regulators of plant biomass degradation in ascomycetous fungi. Biotechnol Biofuels. 2017;10:152. doi: 10.1186/s13068-017-0841-x. [DOI] [PMC free article] [PubMed] [Google Scholar]
- 47.Benocci T, Aguilar-Pontes MV, Kun RS, Seiboth B, de Vries RP, Daly P. ARA1 regulates not only l-arabinose but also d-galactose catabolism in Trichoderma reesei. FEBS Lett. 2018;592(1):60–70. doi: 10.1002/1873-3468.12932. [DOI] [PubMed] [Google Scholar]
- 48.Battaglia E, Klaubauf S, Vallet J, Ribot C, Lebrun M-H, de Vries RP. Xlr1 is involved in the transcriptional control of the pentose catabolic pathway, but not hemi-cellulolytic enzymes in Magnaporthe oryzae. Fungal Genet Biol. 2013;57:76–84. doi: 10.1016/j.fgb.2013.06.005. [DOI] [PubMed] [Google Scholar]
- 49.Kowalczyk JE, Gruben BS, Battaglia E, Wiebenga A, Majoor E, de Vries RP. Genetic interaction of Aspergillus nidulans galR, xlnR and araR in regulating d-galactose and l-arabinose release and catabolism gene expression. PLoS ONE. 2015;10(11):e0143200. doi: 10.1371/journal.pone.0143200. [DOI] [PMC free article] [PubMed] [Google Scholar]
- 50.vanKuyk PA, de Groot MJL, Ruijter GJG, de Vries RP, Visser J. The Aspergillus nigerd-xylulose kinase gene is co-expressed with genes encoding arabinan degrading enzymes and is essential for growth on arabinose and xylose. Eur J Biochem. 2001;268:5414–5423. doi: 10.1046/j.0014-2956.2001.02482.x. [DOI] [PubMed] [Google Scholar]
- 51.Frommhagen M, Sforza S, Westphal AH, Visser J, Hinz SW, Koetsier MJ, et al. Discovery of the combined oxidative cleavage of plant xylan and cellulose by a new fungal polysaccharide monooxygenase. Biotechnol Biofuels. 2015;8:101. doi: 10.1186/s13068-015-0284-1. [DOI] [PMC free article] [PubMed] [Google Scholar]
- 52.Sun J, Tian C, Diamond S, Glass NL. Deciphering transcriptional regulatory mechanisms associated with hemicellulose degradation in Neurospora crassa. Eukaryot Cell. 2012;11(4):482–493. doi: 10.1128/EC.05327-11. [DOI] [PMC free article] [PubMed] [Google Scholar]
- 53.Wang J, Gong Y, Zhao S, Liu G. A new regulator of cellulase and xylanase in the thermophilic fungus Myceliophthora thermophila strain ATCC 42464. 3 Biotech. 2018;8(3):160. doi: 10.1007/s13205-017-1069-y. [DOI] [PMC free article] [PubMed] [Google Scholar]
- 54.Battaglia E, Visser L, Nijssen A, van Veluw J, Wösten HAB, de Vries RP. Analysis of regulation of pentose utilisation in Aspergillus niger reveals evolutionary adaptations in the Eurotiales. Stud Mycol. 2011;69:31–38. doi: 10.3114/sim.2011.69.03. [DOI] [PMC free article] [PubMed] [Google Scholar]
- 55.Jiang Y, Duarte AV, van den Brink J, Wiebenga A, Zou G, Wang C, et al. Enhancing saccharification of wheat straw by mixing enzymes from genetically-modified Trichoderma reesei and Aspergillus niger. Biotechnol Lett. 2016;38(1):65–70. doi: 10.1007/s10529-015-1951-9. [DOI] [PMC free article] [PubMed] [Google Scholar]
- 56.Benoit I, Culleton H, Zhou M, DiFalco M, Aguilar-Osorio G, Battaglia E, et al. Closely related fungi employ diverse enzymatic strategies to degrade plant biomass. Biotechnol Biofuels. 2015;8:107. doi: 10.1186/s13068-015-0285-0. [DOI] [PMC free article] [PubMed] [Google Scholar]
- 57.Langmead B, Trapnell C, Pop M, Salzberg SL. Ultrafast and memory-efficient alignment of short DNA sequences to the human genome. Genome Biol. 2009;10(3):R25. doi: 10.1186/gb-2009-10-3-r25. [DOI] [PMC free article] [PubMed] [Google Scholar]
- 58.Li H, Durbin R. Fast and accurate short read alignment with Burrows-Wheeler transform. Bioinformatics. 2009;25(14):1754–1760. doi: 10.1093/bioinformatics/btp324. [DOI] [PMC free article] [PubMed] [Google Scholar]
- 59.Li B, Dewey CN. RSEM: accurate transcript quantification from RNA-Seq data with or without a reference genome. BMC Bioinform. 2011;12:323. doi: 10.1186/1471-2105-12-323. [DOI] [PMC free article] [PubMed] [Google Scholar]
- 60.Kayala MA, Baldi P. Cyber-T web server: differential analysis of high-throughput data. Nucleic Acids Res. 2012;40(Web Server issue):W553–W559. doi: 10.1093/nar/gks420. [DOI] [PMC free article] [PubMed] [Google Scholar]
- 61.Grigoriev IV, Nikitin R, Haridas S, Kuo A, Ohm R, Otillar R, et al. MycoCosm portal: gearing up for 1000 fungal genomes. Nucleic Acids Res. 2014;42(Database issue):D699–D704. doi: 10.1093/nar/gkt1183. [DOI] [PMC free article] [PubMed] [Google Scholar]
- 62.Cerqueira GC, Arnaud MB, Inglis DO, Skrzypek MS, Binkley G, Simison M, et al. The Aspergillus Genome Database: multispecies curation and incorporation of RNA-Seq data to improve structural gene annotations. Nucleic Acids Res. 2014;42(Database issue):D705–D710. doi: 10.1093/nar/gkt1029. [DOI] [PMC free article] [PubMed] [Google Scholar]
- 63.Altenhoff AM, Dessimoz C. Phylogenetic and functional assessment of orthologs inference projects and methods. PLoS Comput Biol. 2009;5(1):e1000262. doi: 10.1371/journal.pcbi.1000262. [DOI] [PMC free article] [PubMed] [Google Scholar]
- 64.Overbeek R, Fonstein M, D’Souza M, Pusch GD, Maltsev N. The use of gene clusters to infer functional coupling. Proc Natl Acad Sci USA. 1999;96(6):2896–2901. doi: 10.1073/pnas.96.6.2896. [DOI] [PMC free article] [PubMed] [Google Scholar]
- 65.Edgar R, Domrachev M, Lash AE. Gene Expression Omnibus: NCBI gene expression and hybridization array data repository. Nucleic Acids Res. 2002;30(1):207–210. doi: 10.1093/nar/30.1.207. [DOI] [PMC free article] [PubMed] [Google Scholar]
Associated Data
This section collects any data citations, data availability statements, or supplementary materials included in this article.
Supplementary Materials
Additional file 1. Combines Table S1 and Figure S1-S4.
Additional file 2. Differentially expressed CAZy genes involved in plant cell wall degradation.
Additional file 3. Differentially expressed genes involved in sugar transport.
Additional file 4. Differentially expressed genes involved in primary metabolism.
Data Availability Statement
The datasets generated and analyzed during the current study were deposited at the Gene Expression Omnibus (GEO) database [65] with Accession Number: GSE137286.







